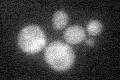
YHR134W
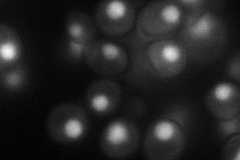
YHR134W
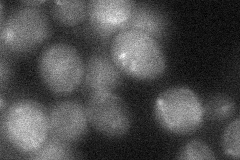
YHR134W

View description
Sumoylated protein of unknown function, identified based on genetic interactions with SMT3; UV-sensitive mutant phenotype and genetic interactions suggest a role in the DNA damage response, processing stalled or collapsed replication forks
Localization:
Intensity:
Fold change:
Significance:
-
C’ GFP library in SD
below threshold17.38 -
N' NOP1pr-GFP in SD
nucleus57.3878 -
N' TEF2pr-mCherry in SD

nucleus12.0665 -
N' NATIVEpr-GFP in SD

punctate20.6413 -
N' TEF2pr-VC and Cyto-VN in SD
below threshold24.8383 -
C’ GFP library in SD+DTT

cytosol18.431.06No -
C’ GFP library in SD+H2O2

cytosol18.641.07No -
C’ GFP library in Starvation Media

cytosol15.960.91No -
C’ GFP library on the background of Pup2-DaMP

below threshold -
C’ GFP library on the background of CCT mutant

below threshold18.64911.07245No
